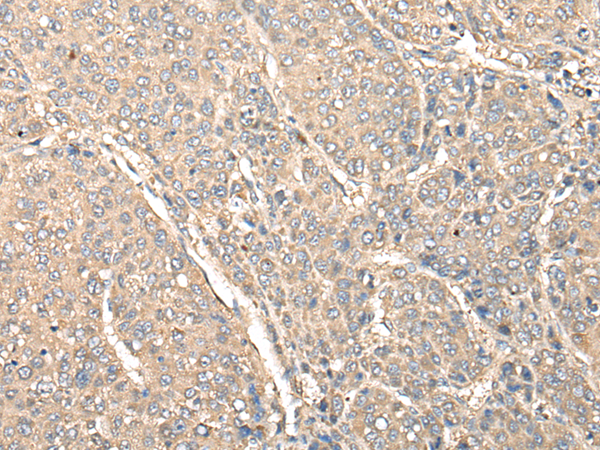

標(biāo) 記 物: Unconjugate
技術(shù)規(guī)格
|
Background: |
Expressed in peripheral macrophages and intestinal myeloid-derived cells, is required for optimal PRR (pattern recognition receptor)-induced signaling, cytokine secretion, and bacterial clearance. Upon stimulation of a broad range of PRRs (pattern recognition receptor) such as NOD2 or TLR2, TLR3, TLR4, TLR5, TLR7 and TLR9, associates with YWHAQ/14-3-3T, which in turn leads to the recruitment and activation of MAP kinases and NF-kappa-B signaling complexes that amplifies PRR-induced downstream signals and cytokine secretion (PubMed:28436939). In the intestine, regulates adherens junction stability by regulating the degradation of CYTH1 and CYTH2, probably acting as substrate cofactor for SCF E3 ubiquitin-protein ligase complexes. Stabilizes adherens junctions by limiting CYTH1-dependent ARF6 activation (PubMed:29420262). |
|
Applications: |
ELISA, IHC |
|
Name of antibody: |
INAVA |
|
Immunogen: |
Fusion protein of human INAVA |
|
Full name: |
innate immunity activator |
|
Synonyms: |
C1orf106 |
|
SwissProt: |
Q3KP66 |
|
IHC positive control: |
Human liver cancer |
|
IHC Recommend dilution: |
50-300 |
購物車
幫助
021-54845833/15800441009
